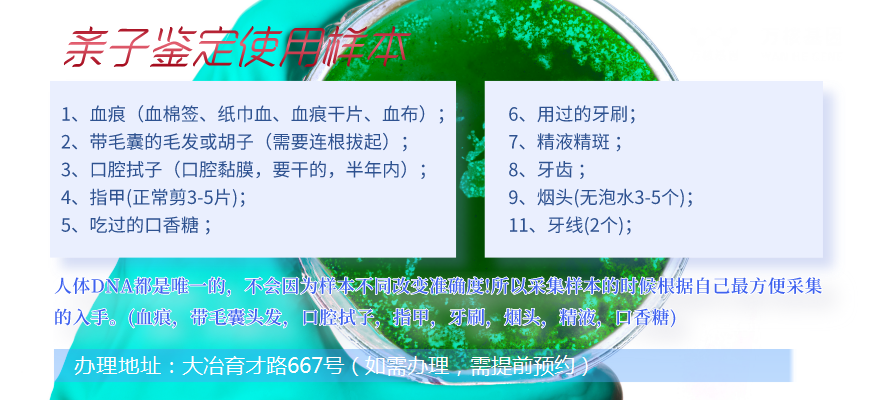

大冶附近做親子鑒定地址,在進行親子鑒定時,建議選擇正規的權威機構進行檢驗,以確保檢測結果準確可靠。
大冶親子鑒定辦理地址:大冶育才路667號(如需辦理,需提前預約),大冶服務地區包括:黃石港區、西塞山區、下陸區、鐵山區、陽新縣、大冶市等周邊城市 大冶,可在線咨詢:無創產前親子鑒定、司法親子鑒定、移民親子鑒定、入戶親子鑒定、中考報告親子鑒定、高考親子鑒定、個人隱私親子鑒定等等咨詢服務和提供專業知識及答復。
通常可以通過以下幾個途徑選擇合適的機構:
1.通過在線搜索:在網上搜索“親子鑒定機構”或“DNA親子鑒定”等關鍵詞,可以得到很多相關機構的信息和評價。可以通過查詢其資質、服務內容、檢測技術等方面的信息來判斷其可靠性。
2.通過推薦:可以向周圍人群、醫生、民政部門、律師等專業人士咨詢建議,并聽取他們的建議和經驗。
3.通過參考實驗室的質量認證和資質證書:通過查看實驗室的質量認證和資質證書,判斷其是否具有經營和檢測親子鑒定的資格和能力。
無論選擇哪種方式,都應該關注機構的可信度和可靠性,同時要查看公司的實驗室技術和實驗室設備,例如,是否有資質證書。最好選擇有經驗和信譽良好的正規機構進行檢測。
大冶親子鑒定正規機構在哪
首先,選擇具有合法資質的機構。合法的親子鑒定機構應該具有相關的執業許可證,例如衛生計生委頒發的《醫療機構執業許可證》、司法部門頒發的《鑒定機構許可證》等。這些許可證明了機構的資質和技術水平,因此在選擇機構時一定要查看機構是否擁有這些資質。
其次,選擇具有良好口碑的機構。可以通過查看機構的*方網站或者社交媒體平臺上的評價和用戶反饋,了解機構的服務質量、專業性和客戶滿意度等方面的信息。同時,也可以通過詢問周圍的朋友或者親戚,尋找他們曾經合作過的親子鑒定機構,并了解他們的評價和感受。
第三,選擇專業的機構。親子鑒定是一項非常專業的測試,需要專業的技術和設備來進行。因此,在選擇機構時一定要了解機構的技術水平和設備情況。一些正規的親子鑒定機構會公開介紹自己的技術和設備,這些信息可以在機構的*方網站或者其他公開渠道上獲得。同時,也可以通過咨詢機構的工作人員,了解機構的測試流程和技術細節。
最后,選擇價格透明的機構。大冶萬核親子鑒定服務中心的價格是2000-5000元左右,價格費用收取執行大冶當地物價局標準。
大冶親子鑒定親子鑒定幾天出結果
親子鑒定的結果出具時間通常取決于實驗室的工作流程和鑒定的樣本類型。一般大冶萬核親子鑒定服務中心,血液樣本的鑒定結果通常需要5-7個工作日,而口腔拭子或者其他非血液樣本的鑒定結果可能需要更長的時間。但是,有些委托人要求加急鑒定服務,可以在較短時間內出具結果,但是需要額外支付費用。
需要注意的是,鑒定結果的出具時間也取決于提交樣本的質量,如樣本的數量、質量、提取是否成功等因素可能會影響鑒定結果的準確性和時間。因此,在實驗室鑒定前,委托人應該咨詢萬核基因,了解鑒定所需的時間和實驗室的工作流程,以便合理鑒定工作人員安排時間和調整計劃。
大冶親子鑒定報告一般包括以下內容:
1.被檢測者信息:報告中會列出被檢測者的基本信息,如姓名、性別、年齡等。
2.實驗方法和數據:報告中會詳細描述實驗方法和數據分析過程,包括采樣方法、樣本標識、實驗過程和分析算法等。
3.DNA對比結果:報告中會列出被檢測者之間的DNA匹配結果,包括檢測到的基因序列、相差的數量、匹配程度等。
4.結論:報告中會給出最終的親子鑒定結果,即二者之間的親緣關系是否存在,以及確定親屬關系的可靠性等指標。
5.簽名和認證:報告會由親子鑒定實驗室簽署并認證,在報告上顯示對應的鑒定機構或檢測人員的姓名、資質等信息。
根據實驗室的報告格式和信息提供要求,報告中可能包含一些附加信息和備注,可以向實驗室咨詢獲取更多的信息。

如何理解親子鑒定
親子鑒定是一種驗證親屬關系的方法,主要用于確定一個孩子與其生物學父母之間的親戚關系。它通過比較被檢測者(父母和孩子)的DNA,找到兩者之間的基因共同點,從而對親緣關系進行判斷。親子鑒定也可以應用到其他親屬關系,如兄弟姐妹之間、祖孫之間、堂兄妹之間的親緣關系的驗證。親子鑒定在法律實踐中具有重要意義,能夠維護家庭關系和遺產分配的公正性。
大冶親子鑒定價格是怎樣的呢
大冶是一個年輕有活力的城市之一,它有很多專門做親子鑒定的機構。對于需要親子鑒定的人來說,價格是一個關鍵的問題。那么,大冶萬核基因的親子鑒定價格是怎樣的呢?
大冶萬核親子鑒定服務機構,辦理地址:大冶育才路667號(如需辦理,需提前預約),大約在2000元至5000元之間,萬核基因為委托人提供更加專業的服務,比如可以為客戶提供DNA采樣服務,提供更加準確的結果。
除此之外,大冶萬核親子鑒定服務機構的私人親子鑒定機構可以提供更加經濟實惠的價格。私人鑒定一般價格在2000元至2600元之間,客戶可以選擇在到現場內進行采樣,也可以選擇讓機構派人到客戶家中采樣,方便又省時。
當然,價格并不是唯一的衡量一個親子鑒定機構好壞的標準。客戶在選擇機構的時候,還應該考慮機構的專業程度、實力以及可靠性等方 總之,大冶的親子鑒定價格是多樣的,客戶可以根據自己的需求和實際情況來選擇合適的機構。



現實生活中大家幾乎都聽說過DNA親子鑒定,也都知道DNA親子鑒定...[詳細]

司法親子鑒定是指需要把鑒定報告提供給法院、公安機關、公證處以及出...[詳細]

在現代社會,越來越多的夫妻、家庭面臨著各種矛盾和糾紛,其中之一便...[詳細]

親子鑒定分為dna司法親子鑒定和個人親子鑒定兩種。如果是個人做親...[詳細]

對于陽新個人隱私親子鑒定來說,其最大的特點就是要確保個人信息的保...[詳細]

親子鑒定利用生物學、遺傳學技術和理論,通過對子代和父代的形態構造...[詳細]

黃石下陸司法親子鑒定是指可以在司法程序中作為證據或證明、使用的親...[詳細]

在dna鑒定辦理過程中,總有父母因為某些特殊原因無法進行親子鑒定...[詳細]

根據做親子鑒定用途的不同,我們可以將親子鑒定分為個人親子鑒定和司...[詳細]

黃石黃石港當地正規的親子鑒定中心對工作人員做到“誰鑒定,告知誰。...[詳細]

大冶附近做親子鑒定地址...[詳細]

黃石西塞山親子鑒定機構地址...[詳細]

黃石鐵山親子鑒定機構地址查詢...[詳細]

黃石下陸做親子鑒定地址...[詳細]

黃石做親子鑒定地址哪里有...[詳細]

黃石黃石港親子鑒定機構地址在哪里...[詳細]

陽新正規親子鑒定機構地址在哪里...[詳細]

黃石下陸司法親子鑒定機構地址...[詳細]

黃石黃石港什么地方做個人親子鑒定...[詳細]

大冶什么地方做個人親子鑒定...[詳細]
推薦檢測中心